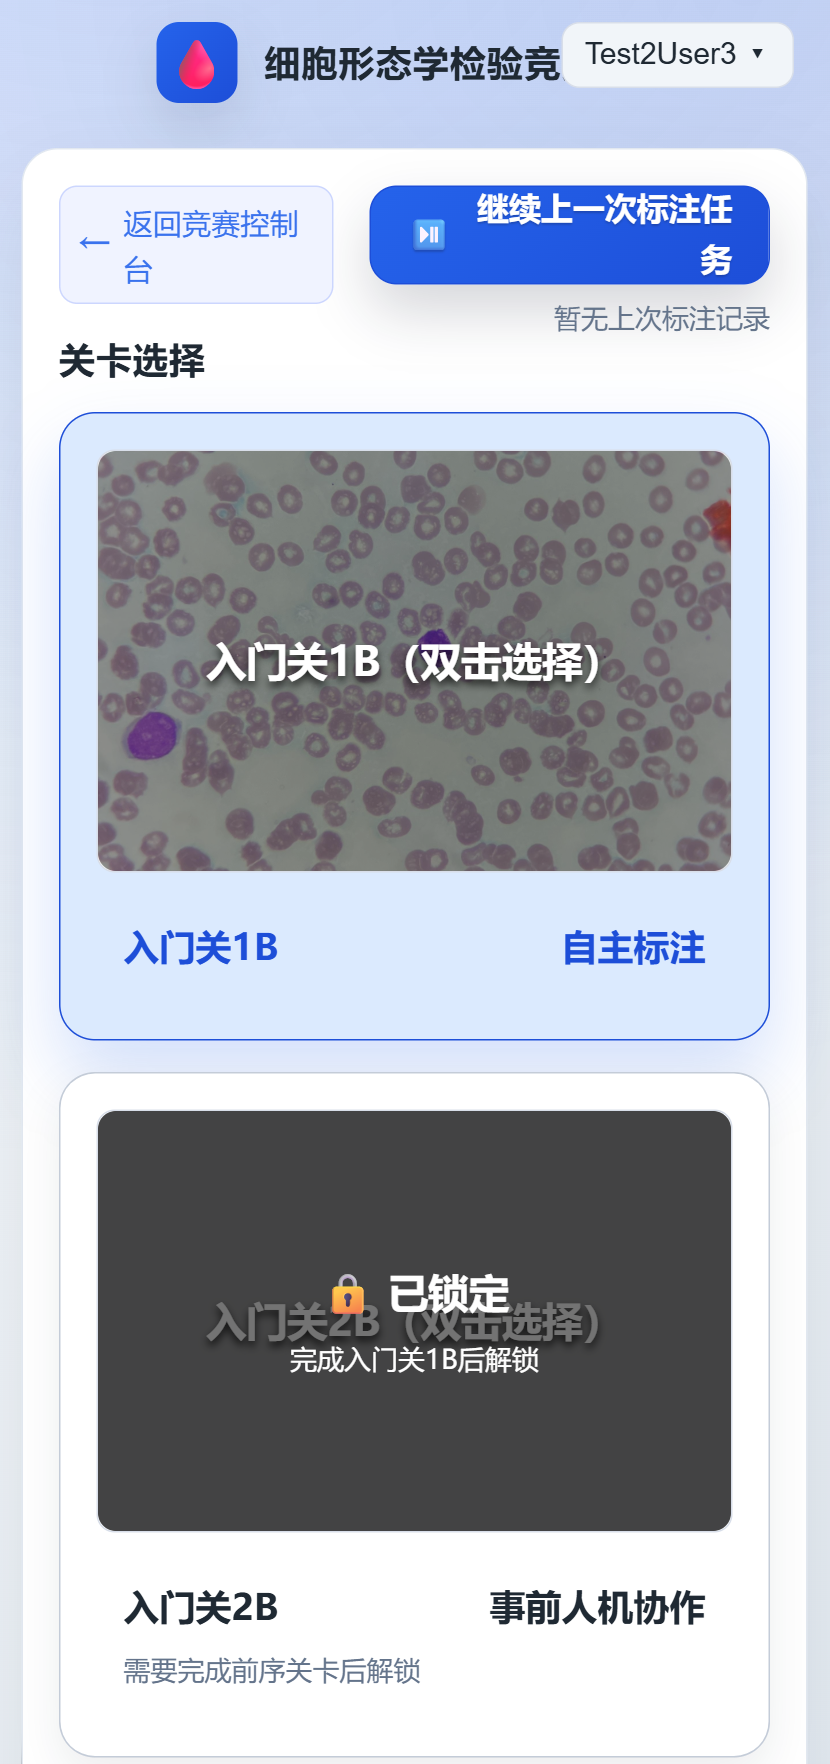
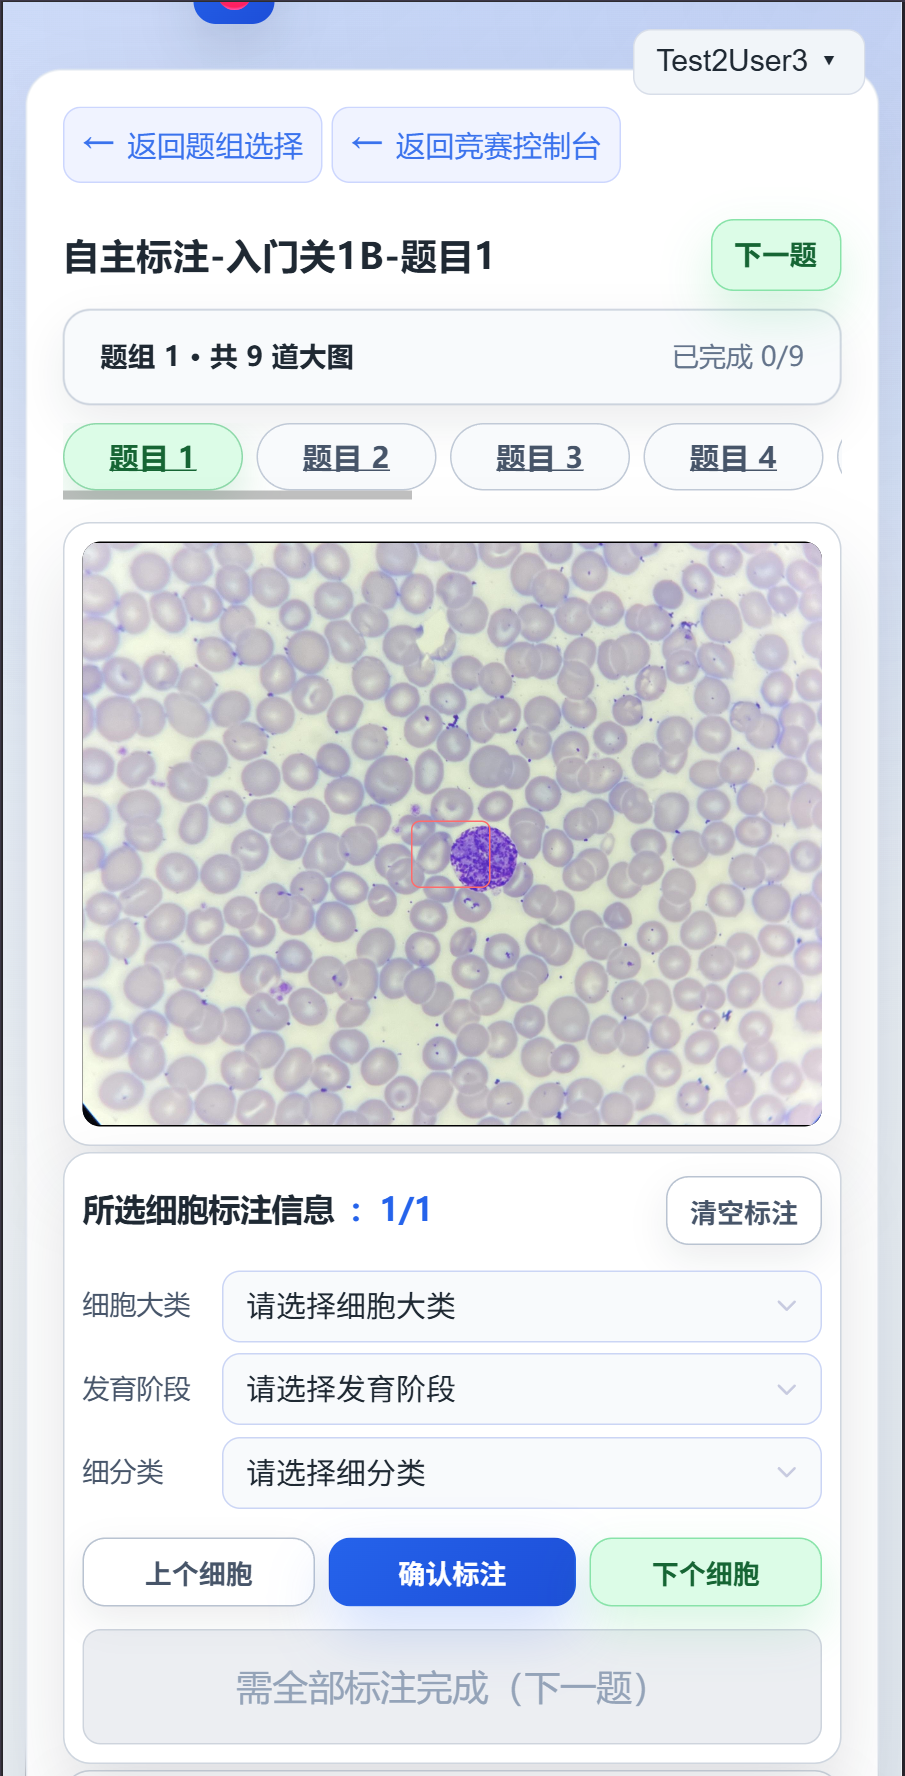
image
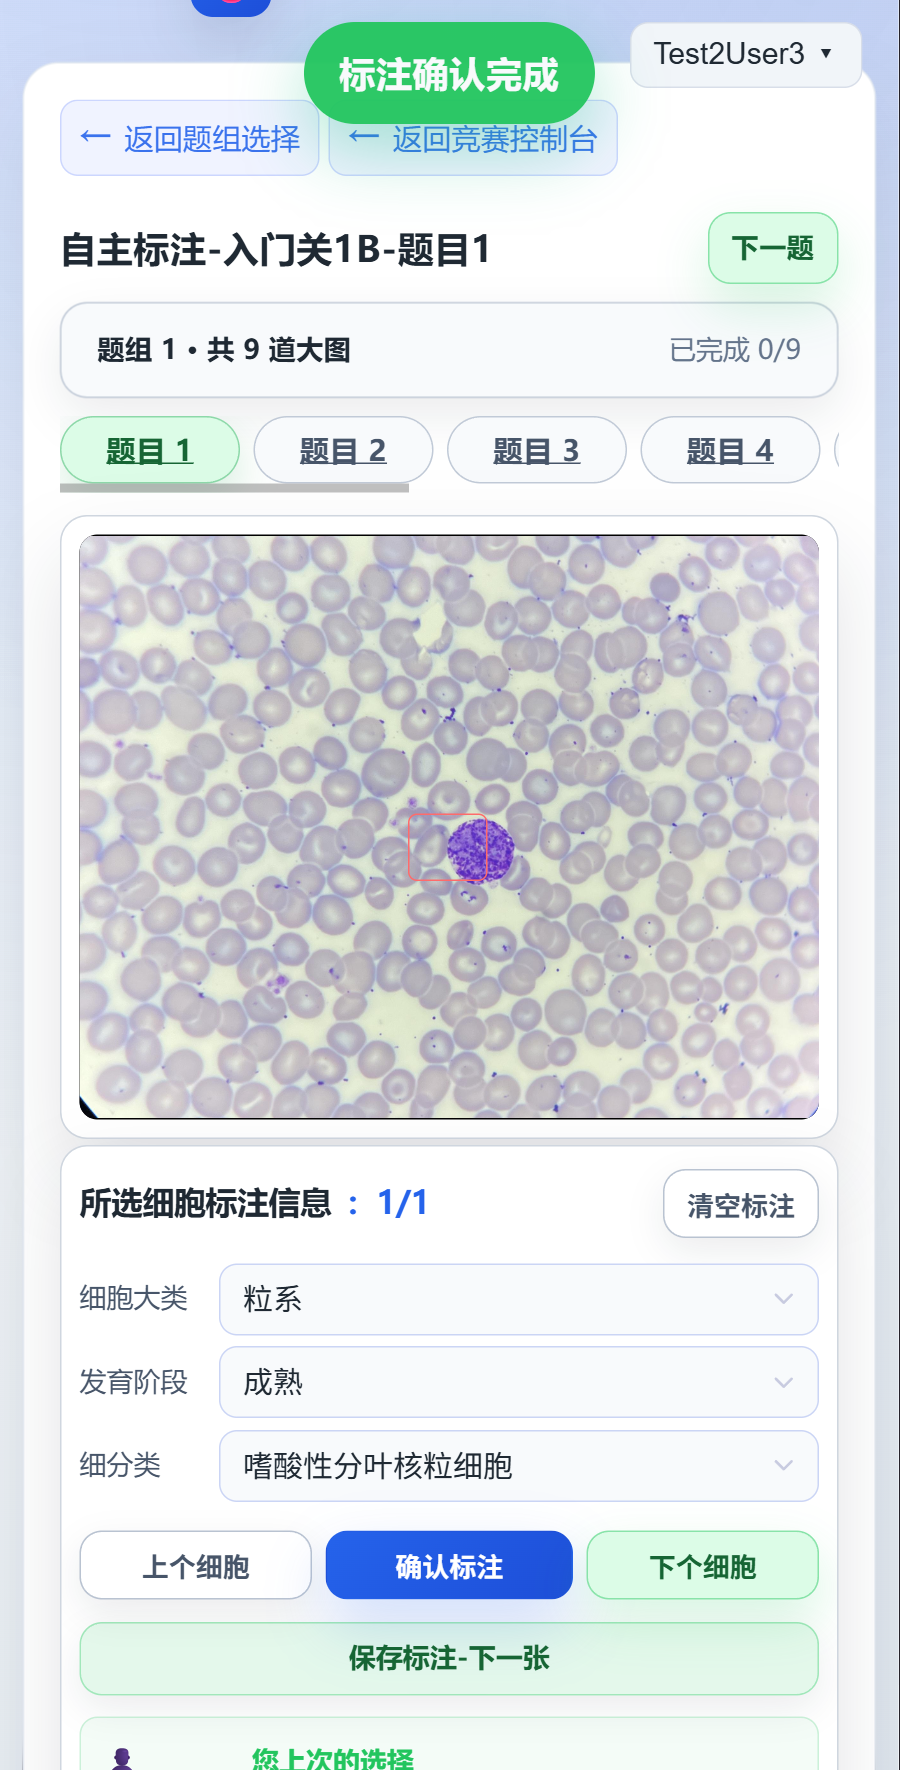
image
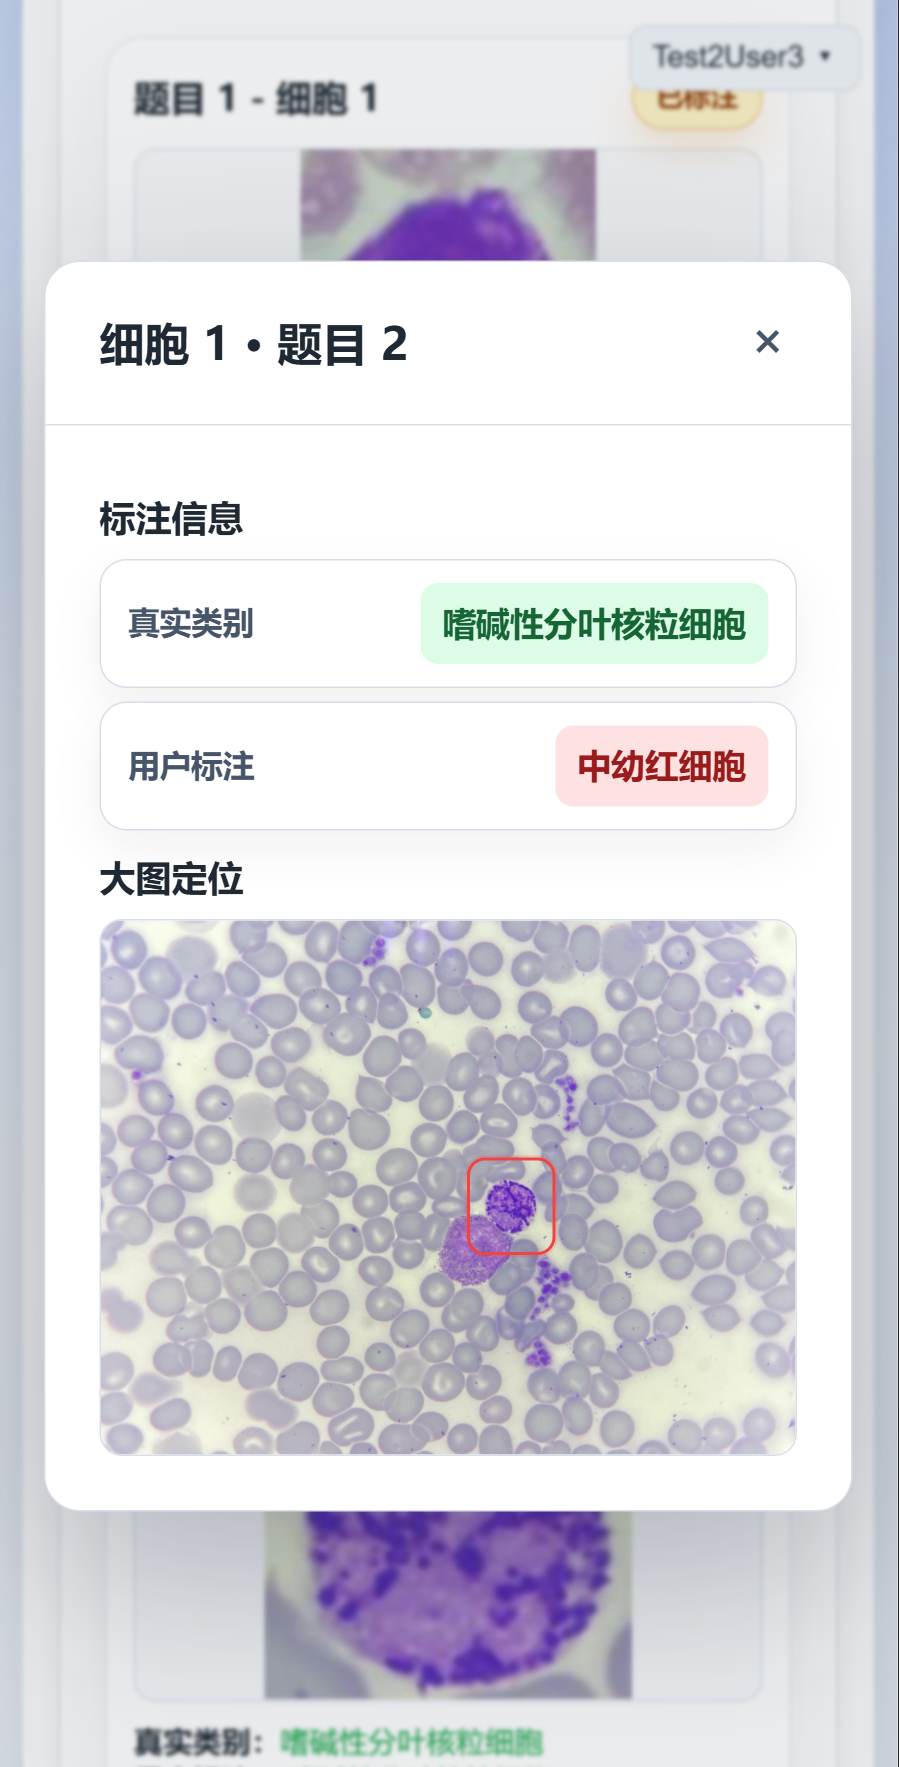

快速开始
参赛者可以参考该文档,快速上手<细胞形态学检验竞赛系统>,整体流程为: - 登录/注册用户 - 开始标注-选择关卡-选择题目 - 标注题目 - 查看数据
实例界面将主要以手机端显示进行说明
登录/注册用户
- 在网页登录界面输入对应的用户名与密码点击登录即可登录。如下图所示。

- 如果还没有账号,则点击“立即注册”进入注册界面,如下图所示输入对应的信息即可完成注册。邀请码可从竞赛活动通知中的查询链接获取。

提示
用户名长度不少于3,且仅可以由英文字符和数字组成。
密码长度不可少于6。
用户名长度不少于3,且仅可以由英文字符和数字组成。
密码长度不可少于6。
注册完毕后进入个人信息填写页电话号码和电子邮箱,请务必填写与报名时相同的信息,以便进行身份核对。
如下图所示,点击“返回竞赛控制台”即可进入控制台界面。

如果在注册时没有填写个人信息,可以在任意界面右上角点击用户名打开菜单后,选择“个人主页”进行填写和修改,也可以进行个人密码的修改:
 |
 |
|---|---|
开始标注-选择关卡-选择题组
- 在上一步中完成登录或注册后点击“返回竞赛控制台”后,便会进行如下图所示的界面。用户可以自动滑动查看下方的“查看进度”功能。

- 点击“开始标注”进入关卡选择界面:
- 选择第一个关卡双击或选择后点击“选择确认”后便会进入题组选择界面:

初始情况下,仅可以选择题组1,选择题组1后,双击或点击“选择确认”即可进入标注界面进行下一步“标注题目”。
| 提示 如果已经在上次的工作标注了题目,则可以通过在“关卡选择”界面右上角的“继续上次标注任务”直接进入上次退出的标注题目界面。 |
|---|

标注题目
进入标注界面之后可以看到如下的界面:
|
 |
|---|---|
首先介绍各个功能区域的作用:
| 红色框选区域 | 点击后用于直接返回“题组选择界面”或“控制台界面” |
|---|---|
| 绿色框选区域 | 用于切换下一题,也就是切换下一张细胞大图 |
| 蓝色区域 | 用于选择题目,如果选项的文字是蓝色的,证明这道题已经标注完成 |
| 黄色区域 | 用于进行类别的选择,选择之后必须要点击“确认标注”才能完成标注; ”上/下个细胞“用于切换选择上/下个细胞进行标注; “所选小图标注信息”后的数字代表着当前细胞小图是第几个/共有几个细胞小图 |
| 黑色区域 | 当当前题目已经全部标注完成时,便可以正常点击之后切换下一题,并保存当前题目所有细胞的标注数据 |
标注流程
- 选择右边“所选小图标注信息”区域中的“细胞大类”、“发育阶段”以及“细分类”的类别:
 |
 |
 |
|---|---|---|
| 三个选项的选项不限制选择顺序,可以直接从细分类中进行类别选择。选择后如果想要重新选择,点击“清空标注”按钮即可。 |
|---|
- 选择好“细分类”后点击“确认标注”即可完成当前细胞的标注,界面上方会出现“标注确认完成”的字样,下方区域会实时更新“您上次的选择”,小图选择区域也会显示“已标注”标记:
|
 |
|---|---|
| 点击“确认标注”后并不代表当前题目的标注信息已经保存至服务器中,必须要点击“保存标注 下一题”才可以保存当前题目的标注数据。 |
|---|
注意!!!如果想要重新标注,可以点击“清空标注”后重新选择标注。
- 标注完成当前题组中的所有题目后,即可返回到“题组选择”界面查看数据。
查看数据
在一个题组中的所有题目完成之后,便可以点击“查看数据”进入题组的数据查看界面:
 |
 |
|---|---|
注意!!!一旦点击“查看数据”后,当前题组中的答案将会被固定下来用于排行榜中的分数计算,因此点击确认之前请慎重。
点击小图之后,便可以查看对应的大图信息(红框部分)
查看排行榜
在任意界面右上角点击用户名打开菜单后,选择“排行榜”即可进入排行榜界面:

排行榜左上角的列表可以选择不同的排行榜进行查看。排行榜每天上午10点和晚上10点刷新一次,具体以页面显示为准。
如排行榜中没有显示您的排名,可能是排行榜未更新,等待更新即可。
常见问题或提示
- 如何查看题组中哪些题目未完成?
在题组选择界面中,未完成的题目选项文字为黑色,已完成的题目选项文字为蓝色。

- 如何重新标注已有标注的细胞?
在标注界面点击“清空标注”,将已选的标注信息清除之后再重新标注。

- 标注过程中不强制必须按照大类-发育阶段-细分类的顺序进行标注,可以直接选择细分类进行标注。
- 网站中如果出现异常的信息提示,如不妨碍标注,可以忽略继续标注;如影响标注,可以尝试进行刷新,请截图通过反馈问卷进行反馈。
-
细胞大图看不清,如何缩放?
在手机端,可以使用双指捏合手势进行缩放细胞大图;在电脑端,如果是笔记本可以通过在触控板进行五指放大缩小的手势进行界面的放大缩小。 在台式机端,需要安装对应的插件进行缩放操作,如Chrome浏览器可以安装“SmoothZoom™”插件进行缩放操作。Edge浏览器中可以安装“Magnifying Glass”插件来实现放大镜查看。 如何安装插件请自行参考对应浏览器的插件安装说明。